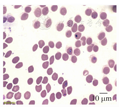

疟原虫感染机体可出现多系统受累,常见临床表现为周期性畏寒、发热、贫血、肾衰竭、代谢性酸中毒、低血糖等。本例患者为输入性重症疟疾,除经典临床表现外,还表现为血小板计数下降、胰酶增高和多尿症的非典型症状,较为少见。

版权归中华医学会所有。
未经授权,不得转载、摘编本刊文章,不得使用本刊的版式设计。
除非特别声明,本刊刊出的所有文章不代表中华医学会和本刊编委会的观点。
患者男,65岁。因"发热2 d,意识模糊半天"于2018年8月4日入院。家属代诉患者8月2日无明显诱因下出现畏寒、发热,最高体温达39.6 ℃,出汗后热退,8月3日中午患者冲澡后出现意识不清,无肢体抽搐、二便失禁,遂被家属送往当地医院,头颅CT检查未见异常,予以对症处理(具体不详)后未见好转,转诊至皖南医学院弋矶山医院。门诊实验室检查示:白细胞计数为9.8×109/L,中性粒细胞比例为0.79,红细胞计数为2.35×1012/L,血红蛋白为72 g/L,血小板计数为19×109/L。光学显微镜检查疟原虫:阳性。胸部CT检查未见明显异常。拟"疟疾,重症疟疾?"收住感染科病房。询问病史,患者发病前曾在非洲尼日利亚工作4个月,1周前回国。否认既往慢性病及传染性疾病史。体格检查:体温为38.0 ℃,心率为110次/min,血压为90/50 mmHg(1 mmHg=0.133 kPa),呼吸为20次/min;神志不清,格拉斯哥昏迷评分为10分,体格检查不合作,对答不能,全身皮肤及黏膜正常,未见皮疹、皮肤黄染和皮下出血点;颈软,无颈强直;双肺未闻及明显干湿性啰音;心律齐,各瓣膜听诊区未闻及病理性杂音;生理反射正常,病理反射未引出。入院后予以青蒿琥酯120 mg/d静脉推注抗疟原虫,氢化可的松100 mg/d静脉滴注抗感染,预防性抗感染、护胃、维持水电解质酸碱平衡等支持对症处理,因血小板计数重度减少,遂输注1个治疗量血小板。入院后复检疟原虫结果仍为阳性,芜湖市CDC和皖南医学院弋矶山医院进一步确诊为恶性疟原虫感染(图1和图2)。入院实验室检查:ALT为17.0 U/L,AST为23.0 U/L,总胆红素为42.5 μmol/L,尿素氮为18.4 mmol/L,肌酐为138.7 μmol/L,尿酸为344.0 μmol/L,钾为4.65 mmol/L,钠为138.4 mmol/L;pH值为7.34,二氧化碳分压为19.2 mmHg,氧分压为93.9 mmHg,乳酸为8.0 mmol/L,氧饱和度为96.4%,碳酸氢根为13.6 mmol/L;ESR为65.0 mm/h;C反应蛋白为286.2 mg/L,胰腺功能、凝血功能、输血前常规、粪便常规+隐血、尿常规指标均未见异常。第3天患者体温恢复正常。第5天患者神志清楚,对答切题,格拉斯哥昏迷评分为15分。但检验科危急值示:尿素氮31.8 mmol/L,肌酐为481.1 μmol/L,淀粉酶为322.0 U/L,脂肪酶为404.8 U/L;此时患者仅诉全身乏力,无腹痛、腹泻、呕吐等不适。请肾内科、消化内科会诊后增加补液量、碳酸氢钠静脉滴注、生长抑素泵入,嘱患者继续禁食。并行床边急腹症超声检查示:肝、胆、胰、脾和泌尿系统均未见明显异常。第11天实验室检查:白细胞计数为7.9×109/L,红细胞计数为1.49×1012/L,血红蛋白为47 g/L,血小板计数为175×109/L;ALT为40 U/L,总胆红素为16.96 μmol/L,尿素氮为6.60 mmol/L,肌酐为140.1 μmol/L,淀粉酶为160.0 U/L,脂肪酶为156.4 U/L;疟原虫镜检为阴性。在第12、13、16天输注红细胞悬液(每次分别为400 mL、300 mL、400 mL)以改善贫血。入院第16天发现患者前几天的尿量明显增多,特别是8月16日24 h尿量高达5 200 mL,故减少输入量,嘱患者少饮水。同时为排除合并尿崩症的可能,行垂体MRI、促肾上腺皮质激素(adrenocorticotropic hormone,ACTH)、催乳素(prolactin)等检查,但均未见异常。第21天(8月24日)患者仅诉双下肢稍乏力,余无特殊不适,生命体征正常,24 h尿量降至2 000 mL,复查血常规、肝、肾、胰腺功能等均正常,患者好转出院。2018年10月7日和11月20日2次电话回访患者均无任何不适。




注:1为患者血样的扩增产物;2为恶性疟特异性的扩增产物;3为恶性疟和间日疟混合的扩增产物;4为间日疟的特异性扩增产物;5为标志物
疟原虫感染人体后常见临床表现为周期性畏寒发热、贫血、肾衰竭、代谢性酸中毒、低血糖、昏迷和抽搐惊厥等[1,2]。根据本例患者流行病学史、辅助检查和典型临床表现,输入性重症疟疾(恶性疟)诊断明确,但其诊治过程中出现的血小板计数减少、胰酶增高和多尿现象则在国内外各诊治指南中并无相关介绍,特别是后两者属罕见并发症。
疟疾患者血液系统的变化除贫血外,血小板减少症亦不可忽视[3,4,5]。据报道,血小板减少症发生率为71%~93%[4] 。在动物模型实验中首先证明了在血液检测到疟原虫之前,血小板计数已开始下降,当血液中发现疟原虫时,机体血小板计数已明显低于正常值,且不随血液内疟原虫密度高低变化而改变。随后在对恶性疟和间日疟患者的临床观察中同样发现这种现象[3,4]。研究表明,血小板减少症是重症疟疾标志之一,并发血小板计数减少时,患者住院的风险增加2.4倍,死亡风险增加4.7倍[5]。血小板计数下降原因目前考虑为疟原虫作为抗原刺激机体,产生外周血小板相关性抗体,其与血小板结合后流经脾脏时与巨噬细胞充分接触,大量血小板被吞噬,造成血小板破坏过多;脾脏吞噬大量含有疟原虫的红细胞,引起脾病理性的肿大,脾功能亢进,吞噬能力进一步增强;还有可能为骨髓功能、抗氧化反应、补体反应等原因[3,4,5]。
本例重症疟疾患者虽未达到急性胰腺炎诊断标准,但胰酶的升高提示有胰腺的损伤。急性胰腺炎是疟疾的一种罕见并发症,但国外疫区的报道正逐年增加。发病机制主要是由于疟原虫在红细胞内繁殖,使受感染的红细胞体积增大,从而较易黏附包括胰腺在内的各脏器微血管内皮细胞上,使局部组织发生缺血、缺氧改变,其次重症患者的应激、高代谢状态可进一步加重胰腺局部缺血损伤等[2]。因此对于疟疾患者,特别是恶性疟患者,不管伴不伴腹痛,当胰酶增高且病情进展时,需警惕急性胰腺炎的发生。Mahdi等[6]报道了1例恶性疟患者在青蒿琥酯治疗第8天突发腹痛、呕吐等症状,提示急性胰腺炎,考虑为青蒿琥酯治疗的不良反应,可能与青蒿琥酯的有毒代谢物积累、细胞毒性和超敏反应等相关。关于青蒿琥酯能否诱发急性胰腺炎尚需未来更深入的研究。
虽然本患者垂体MRI、ACTH、催乳素均未见异常,但结合该患者特点:①有意识不清的脑型疟症状;②在肾功能恢复1周余后才出现持续多尿,不支持肾损伤所致病理改变;③减少液体输入量后尿量明显减少。因此,推测患者并发部分中枢性尿崩可能。国内尚鲜见疟疾并发完全性尿崩症的报道。Grimwade等[7]研究的411例疟疾患者中有37例出现多尿现象,其中10例最终诊断为尿崩症。疟疾合并尿崩症机制尚不明确,推测可能与神经垂体因红细胞黏附聚集继发微循环梗死,抗利尿激素分泌异常,肾小管重吸收功能受损等多种因素相关。
Zaki和Shanbag[1]总结了1960年至2002年报道的疟疾病例的各种非典型表现,发现仅有50%~70%患者会出现周期性寒战发热、贫血等典型表现。特别是在疟疾流行地区,机体免疫失衡、抗疟药物滥用和抗疟药物耐药性增加导致疟疾逐渐呈现出不同寻常的临床特征。例如非典型消化系统并发症除急性胰腺炎外,急腹症、急性肝衰竭、脾破裂、消化道出血、十二指肠穿孔和肠梗阻等均有报道;疟疾患者血液学反应除贫血、血小板减少外,还可以出现噬血细胞综合征、脑静脉血栓形成和单核细胞增多症等少见现象[1,3]。
疟疾的临床表现复杂,特别是恶性疟原虫引起的重症疟疾可出现多系统、多脏器损伤[1,3]。因此,需密切关注病情变化,监测多项相关指标,警惕非典型疟疾并发症的发生,有助于尽早判断病情。
所有作者均声明不存在利益冲突